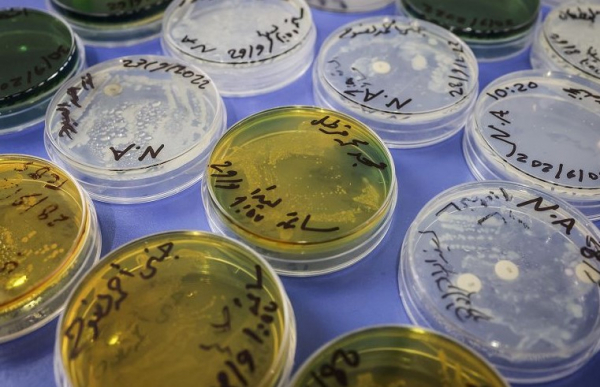

Контроль и профилактика холеры в Казахстане
О текущей ситуации с холерой в мире и в Казахстане, а также о мерах, предпринимаемых для предотвращения её распространения сообщил Департамент санитарно-эпидемиологического контроля на транспорте, передает DKNews.kz.
По данным Всемирной организации здравоохранения (ВОЗ), общемировой рост заболеваемости холерой наблюдается с 2021 года. В 2022 году ВОЗ сообщила о регистрации 473 000 случаев заболевания, что более чем в два раза выше соответствующего показателя за 2021 год. В 2023 году ситуация продолжила ухудшаться, и количество случаев продолжает расти, угрожая новым регионам, где холера ранее не наблюдалась.
В 2024 году зарегистрировано 94 229 случаев заболевания холерой, из которых 1 685 завершились летальным исходом. Вспышки холеры были зафиксированы в 16 странах Африки, 5 странах Азии, а также в США, Бразилии и Гаити. По оценкам исследователей, в мире ежегодно происходит от 1,3 до 4,0 миллиона случаев заболевания холерой и 21 000–143 000 случаев смерти от этой болезни.
Многие из этих вспышек связаны с экстремальными климатическими явлениями, которые могут приводить к нарушению водоснабжения и вынужденным перемещениям населения. Ожидается, что в будущем частота наводнений, засух, штормов и перемещений увеличится. Если не принять меры, рост населения и урбанизация могут привести к удвоению числа случаев холеры в ближайшие 20 лет.
С начала 2024 года в Казахстане зарегистрировано 3 завозных случая холеры. Два случая были зафиксированы у граждан Российской Федерации и один у гражданина Киргизии. Последние завозные случаи холеры в Казахстане отмечались в 2017 и 2019 годах.
Для контроля и предотвращения завоза особо опасных инфекционных заболеваний, включая холеру, на территории Казахстана функционирует сеть санитарно-карантинных пунктов. Эти пункты расположены во всех крупных международных транспортных узлах, включая аэропорты, железнодорожные станции и порты.
Для защиты от холеры крайне важно применять следующие меры предосторожности при поездках в страны, подверженные риску:
- Использование безопасной воды: Отдавайте предпочтение закрытой и безопасной воде. Избегайте употребления воды из сомнительных источников и пользуйтесь бутилированной или кипячёной водой. Важно следить за тем, чтобы вода была проверена на отсутствие загрязнений и соответствовала санитарным нормам.
- Избегание льда: Не используйте лёд в напитках, безопасность которых не гарантирована.
- Соблюдение гигиены: Часто мойте руки с мылом и чистой водой, особенно до и после приготовления пищи, еды, посещения туалета, кормления детей и ухода за больными.
- Обработка поверхностей: Туалеты, ванные комнаты и раковины должны быть очищены. Используйте дезинфицирующие средства для устранения бактерий и вирусов, особенно в местах с высоким уровнем влажности.
- Безопасное питание: Ешьте только свежеприготовленную или закрытую пищу. Избегайте употребления сырого или недоваренного мяса, моллюсков и морепродуктов.
- Покупать продукты в фабричной упаковке в специализированных магазинах. Это гарантирует, что продукты прошли контроль качества и соответствуют санитарным нормам.
Департамент санитарно-эпидемиологического контроля на транспорте призывает всех граждан соблюдать меры предосторожности и обращаться за медицинской помощью при первых признаках заболевания. Безопасная питьевая вода, надлежащие санитарные условия и гигиена являются ключевыми факторами в предотвращении холеры.










